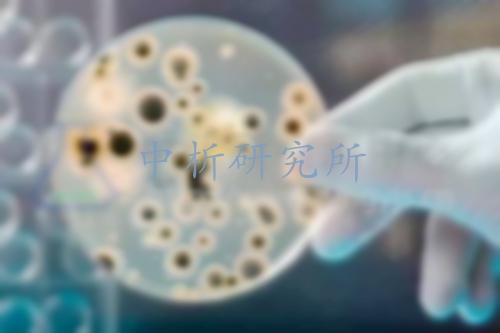
嗜肺軍團菌檢測

嗜肺軍團菌檢測
1對1客服專屬服務,免費制定檢測方案,15分鐘極速響應
發布時間:2025-07-25 08:49:03 更新時間:2025-11-04 08:48:28
點擊:443
作者:中科光析科學技術研究所檢測中心

1對1客服專屬服務,免費制定檢測方案,15分鐘極速響應
發布時間:2025-07-25 08:49:03 更新時間:2025-11-04 08:48:28
點擊:443
作者:中科光析科學技術研究所檢測中心

軍團菌(Legionella):是一種廣泛存在于自然界中的機會致病菌,能引起以發熱和呼吸道癥狀為主的疾病稱軍團菌病,其中最為多見和嚴重的臨床類型為以肺部感染為主,同時伴有全身多系統損害的軍團菌肺炎。
空調冷卻水,集中空調冷凝水,通風系統,淋浴水,
1GB/T 18204.3-2013公共場所衛生檢驗方法 第3部分:空氣微生物
2ISO/TS 12869-2012水質 通過定量聚合酶鏈反應(QPCR)進行集中和遺傳因子發揮軍團菌和/或嗜肺軍團菌的檢查和量化
3SN/T 3306.4-2012國境口岸環介導恒溫擴增(LAMP)檢測方法 第4部分:嗜肺軍團菌
4SN/T 4283.5-2015國境口岸微孔板基因芯片檢測方法第5部分:肺炎支原體、肺炎衣原體及嗜肺軍團菌
1、郵寄樣品或寄送取樣。
2、收到嗜肺軍團菌檢測樣品后,工程師將免費進行初始測試。
3、應根據測試項目和測試方法進行報價。
4、支付測試費用并進行實驗。
5、完成實驗并分析測試數據。
6、后期測試報告,后期技術支持。
1,中析研究所嗜肺軍團菌檢測中心檢測周期短、成本低、數據報告準確。
2,多臺進口檢測設備,一支以博士生為主的工程師隊伍。
3,支持現場采樣和樣品發送測試。
4,行為公正、方法科學、數據準確、服務效率。

證書編號:241520345370

證書編號:CNAS L22006

證書編號:ISO9001-2024001















版權所有:北京中科光析科學技術研究所京ICP備15067471號-33免責聲明